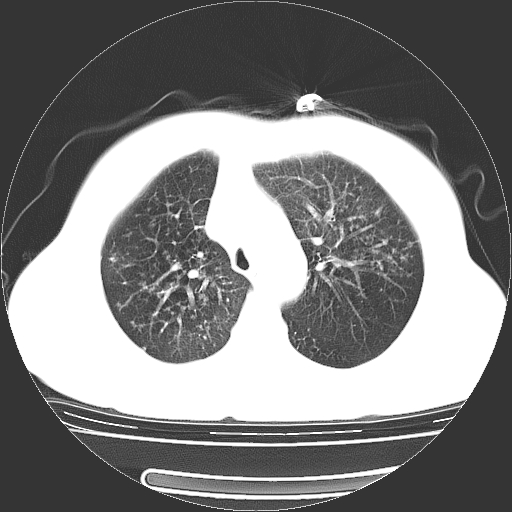
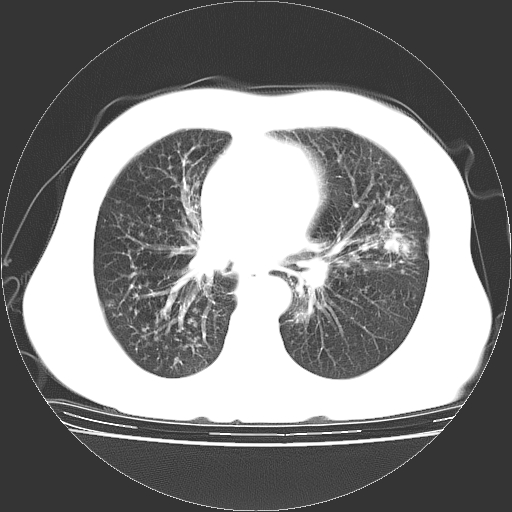
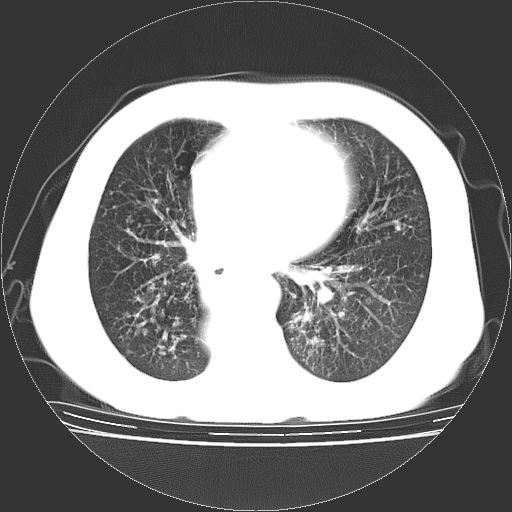

以下是引用卜一在2009-11-11 7:12:00的发言:[br]一元论:内膜结核伴下肺阻塞性肺炎并双肺播散!另:主动脉夹层。右侧少量胸腔积液。
以下是引用听海观潮2008在2009-11-10 23:37:00的发言:[br]1.左上肺结核,部分纤维化。右肺中下叶部分肺不张,内见液化、坏死及点状钙化,右中下叶支气管壁增厚、管腔狭窄,见多个点状钙化,结合临床考虑支气管内膜结核,建议痰检查抗酸杆菌并参考血沉。两肺多个小圆点状高密度灶,境界模糊,多考虑结核肺内播散。但本人年龄较大首先应支气管镜检以除外右肺癌。[br]2.胸主动脉夹层。[br]
以下是引用地球上的老实人在2009-11-11 0:33:00的发言:[br]1、右肺占位,考虑周围型ca 。[br]2、右下肺软组织密度肿块影,考虑肺隔离征。[br]3、两肺肺结核(右肺下叶背段及左肺)。[br]4、主动脉夹层。[br]5、右侧少量胸腔积液。
| 欢迎光临 医影在线 (http://bbs.radida.com/bbs/) | Powered by Discuz! X3.2 |